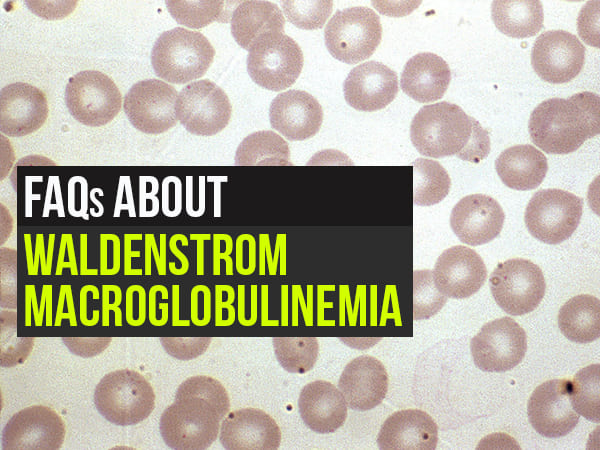

Latest Updates
-
Purported Video of Muslim Mob Lynching & Hanging Hindu Youth In Bangladesh Shocks Internet -
A Hotel on Wheels: Bihar Rolls Out Its First Luxury Caravan Buses -
Bharti Singh-Haarsh Limbachiyaa Welcome Second Child, Gender: Couple Welcome Their Second Baby, Duo Overjoyed - Report | Bharti Singh Gives Birth To Second Baby Boy | Gender Of Bharti Singh Haarsh Limbachiyaa Second Baby -
Bharti Singh Welcomes Second Son: Joyous News for the Comedian and Her Family -
Gold & Silver Rates Today in India: 22K, 24K, 18K & MCX Prices Fall After Continuous Rally; Check Latest Gold Rates in Chennai, Mumbai, Bangalore, Hyderabad, Ahmedabad & Other Cities on 19 December -
Nick Jonas Dancing to Dhurandhar’s “Shararat” Song Goes Viral -
From Consciousness To Cosmos: Understanding Reality Through The Vedic Lens -
The Sunscreen Confusion: Expert Explains How to Choose What Actually Works in Indian Weather -
On Goa Liberation Day 2025, A Look At How Freedom Shaped Goa Into A Celebrity-Favourite Retreat -
Daily Horoscope, Dec 19, 2025: Libra to Pisces; Astrological Prediction for all Zodiac Signs
10 FAQs About Waldenstrom Macroglobulinemia (Cancer Of The White Blood Cells)
Waldenstrom Macroglobulinemia (WM), pronounced as (mak-roe-glob-u-lih-NEE-me-uh) is a cancer type that starts in the white blood cells or lymphocytes. It is a slow-growing type of cancer that belongs to the subtype of non-Hodgkin lymphoma.
WM is considered rare cancer with a prevalence rate of around 2-3 per cent per million cases per year. In this article, we will look into some of the frequently asked questions related to WM. Take a look.
Question 1: What is WM?
Answer: WM is a type of cancer that begins in the B-cells, a type of white blood cells (WBCs). When infections enter our body, these cells change into plasma cells and make immunoglobins or say, antibodies that help kill or fight off infections or other foreign bodies.
Question 2: Who is more prone to WM?
Answer: People between the age 60-70 are more likely to get WM. It is twice more common in males than in females. Also, WM is likely to be found in people who belong to the Caucasians race.
Question 3: What causes WM?
Answer: WM is caused due to mutation in the DNA of WBCs or lymphocytes. The exact cause of the mutation is still unknown. The B-cells are mainly produced in the bone marrow. Due to mutation, they start growing abnormally and crowd the area causing problems in the production of other healthy blood cells such as red blood cells (RBCs), platelets and also WBCs. The lower numbers of RBCs, WBCs and platelets cause multiple symptoms such as anaemia, weakness and weaker immune system.
Question 4: What are the symptoms of WM?
Answer: As WM is a slow-growing cancer, it may not cause symptoms at first. Common symptoms of WM include:
- Anaemia
- Fever and headache
- Night sweats
- Weight loss
- Easy bruising
- Blurring or loss of vision
- Bleeding from gums and nose
- Breath shortness
- Numbness
- Impaired blood circulation
- Difficulties in coordination movement
- Pain in hands and feet
Microcytic Anemia: Symptoms, Causes, Risk Factors, Treatment, And Prevention

Question 5: Is WM inherited?
Answer: Most of the patients of WM do not have a history of the condition. They develop WM due to genetic mutation in the DNA of WBCs, likely caused due to the combination of both genetic and environmental factors. Around 20 per cent of individuals with WM may have family members of the disorder or other cancer types that include dysfunction of WBCs.
Question 6: How is WM diagnosed?
Answer: WM may be asymptomatic at the beginning. Therefore, it cannot be diagnosed properly until the symptoms start. Common diagnostic methods include:
- Blood test: To find out the levels of healthy blood cells and detect IgM proteins which are signs of cancer. Sometimes, WM is diagnosed as part of a routine checkup when the count of healthy blood cells is found low.
- Bone marrow biopsy: To analyse the cancer cells along with any kind of genetic mutation.
- CT scan:To lookout for the spread of cancer cells in the nearby areas.
World Sickle Cell Day (19 June): What Is Cord Blood Banking? Know More About Its Pros And Cons
Question 7: Is there a cure for WM?
Answer: No, there's still no cure for WM. However, due to the advancement of medical science, better treatment methods are available to manage its symptoms and improve the quality of life in people affected by the conditionfor many years.
Question 8: What treatment methods are approved for WM?
Answer: WM cannot be cured but can be treated or managed. The treatment methods vary from person to person depending on the severity of the condition. Some effective treatments include:
- Plasma exchange: It includes replacement of abnormal plasma with healthy blood plasma.
- Chemotherapy: Using drugs to kill growing cells.
- Bone marrow transplant (stem cell transplant): Infusion of healthy bone marrow stem cells after replacing damaged bone marrow so that the body can start making healthy blood cells.
- Drug combinations: Medications to stimulate the functioning of the immune system to fight against cancer cells. This method is carried out in combination with chemotherapy.
17 Safe And Effective Home Remedies For Foot Pain
Question 9: When should a person with WM start the treatment?
Answer: A person should consult a medical expert or start the treatment of WM as soon as their blood test results show high IgM protein levels, as it may be a sign of cancer. Sometimes, the symptoms may start late, therefore, starting the treatment after blood tests result could help decrease the health risk, which may get higher after the arrival of symptoms.
Question 10: Is a person with WM at in increased risk of other cancer types?
Answer: Many studies have concluded that people with WM are also at increased risk of other cancer types such as thyroid, prostate, skin and breast. It is because there are higher chances of the spread of cancer cells to other body parts. Routine checkups and monitoring of symptoms can help decrease the risk of other types of cancer.
Disclaimer: The information provided in this article is for general informational and educational purposes only and is not intended as a substitute for professional medical advice, diagnosis, or treatment. Always seek the advice of your physician or a qualified healthcare provider with any questions you may have regarding a medical condition.



Click it and Unblock the Notifications











